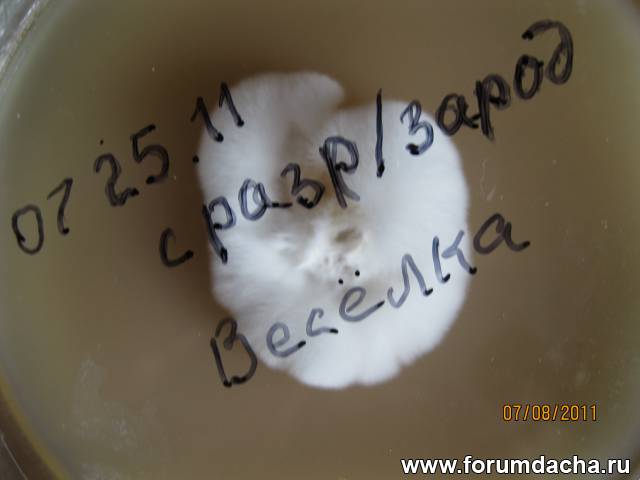
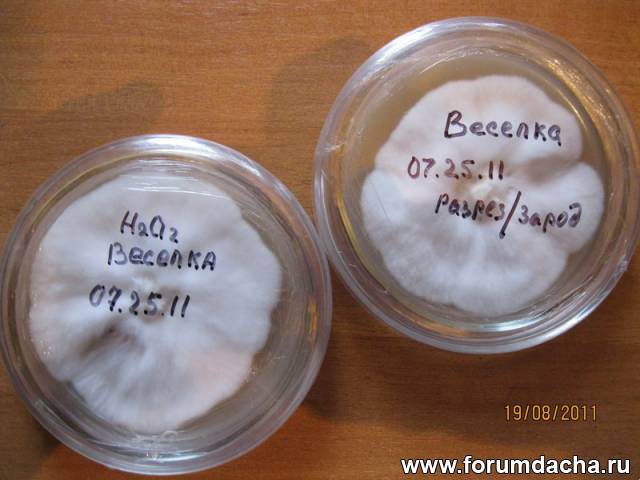
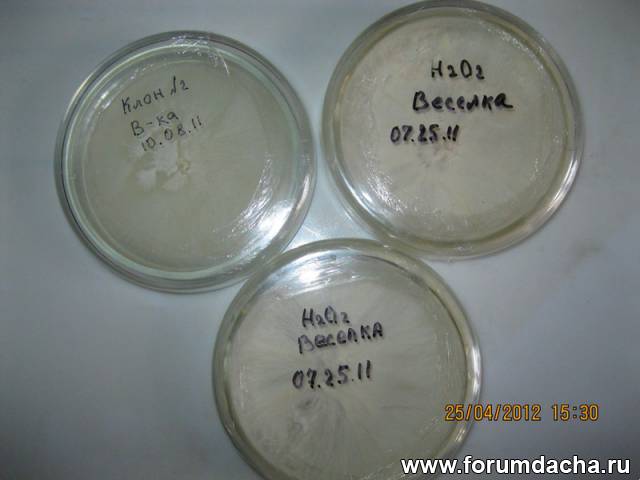

|

| Автор |
Сообщение |
Александр Кузнецов |
|
|
Зарегистрирован: 23.10.2009
Сообщения: 6776
Откуда: Алтайский край, р.ц.Алтайское
|

|
16-04-2012, 17:40 |
 Заголовок сообщения: Выращивание мицелия гриба Веселки на питательных средах. |
| А.Ю. писал(а): |
А кто-нибудь пробовал выращивать мицелий веселки на желе этого гриба?
На днях разморозил гриб и очистил его от желе. За пару дней стояния на открытом воздухе на кухонном столе на этом желе поселилась плесень и видимо очень комфортно себя чувствовала. Также знаю,. что иногда при проращивании спор грибов используют желе из агар-агара. Вот и подумалось может попробовать заселиь споры на это грибное желе. Только как обеспечить стерильность процесса? |
Выращиванием мицелия на питательных средах из моих знакомых занимается Савелий http://www.forumdacha.ru/forum/profile.php?mode=viewprofile&u=4601
Попробуйте попросить его рассказать об этом?
А для этого я открываю отдельную тему: Выращивание Веселки на питательных средах.
Последний раз редактировалось: Александр Кузнецов (27-04-2012, 20:19), всего редактировалось 2 раз(а)
|
|
Александр Кузнецов |
|
|
Зарегистрирован: 23.10.2009
Сообщения: 6776
Откуда: Алтайский край, р.ц.Алтайское
|

|
16-04-2012, 17:45 |
 Заголовок сообщения: |
|
|
Александр Кузнецов |
|
|
Зарегистрирован: 23.10.2009
Сообщения: 6776
Откуда: Алтайский край, р.ц.Алтайское
|

|
17-04-2012, 01:33 |
 Заголовок сообщения: |
|
|
Александр Кузнецов |
|
|
Зарегистрирован: 23.10.2009
Сообщения: 6776
Откуда: Алтайский край, р.ц.Алтайское
|

|
27-04-2012, 20:16 |
 Заголовок сообщения: |
Есть интересный опыт культивирования Веселки у Савелия http://www.forumdacha.ru/forum/profile.php?mode=viewprofile&u=4601 на агаровых средах и субстрате органическом, с последующим переселением в гряды земляничные под мульчу.
Присоединяюсь к вопросу А.Ю. "о культивации на агаровых средах", то есть по первому этапу-культивации мицелия? Савелий, можете пояснить как с этим работать?
Я знаю что у Вас и фото есть этого процесса?!
|
|
saulius |
|
|
Зарегистрирован: 25.10.2009
Сообщения: 239
|

|
27-04-2012, 20:54 |
 Заголовок сообщения: |
А зачем на агаровых, если и на опилках прекрасно растет?
|
|
Александр Кузнецов |
|
|
Зарегистрирован: 23.10.2009
Сообщения: 6776
Откуда: Алтайский край, р.ц.Алтайское
|

|
27-04-2012, 23:06 |
 Заголовок сообщения: |
| saulius писал(а): |
| А зачем на агаровых, если и на опилках прекрасно растет? |
Я так понимаю, это когда есть плодовое тело гриба (в стадии яйца), и нет мицелия, или возможности его "поймать" в природе. Тогда можно культивировать мицелий вначале на агаровой среде (кусочком из плодового тела гриба), а потом уже на органическом субстрате?
Может Савелий пояснит, зачем он это делал? И как?
|
|
saulius |
|
|
Зарегистрирован: 25.10.2009
Сообщения: 239
|

|
28-04-2012, 09:42 |
 Заголовок сообщения: |
В нижней части "яйца" есть "нитка" мицелия. Прошлой осенью положил такую нитку в пакетик с влажными опилками и она начала расти, ветвиться. Потом все куда то исчезло, может червяк какой то попал в пакетик и все сьел, но факт- мицелий размножается и от маленькой нитки. В опилках.
|
|
Савелий |
|
|
Зарегистрирован: 26.04.2012
Сообщения: 20
|

|
28-04-2012, 19:42 |
 Заголовок сообщения: |
Приветствую всех читающих эту тему. Начну с того, что Веселка заставила меня, искать её, причем лихорадочно Гриб на стадии многим известного "Яйца", заинтересовал меня, исключительно как лекарственное средство. . Наступило время, когда родному человеку поставили диагноз по онкологическому заболеванию, попытался купить препараты Веселки, но это оказалось очень не просто, вернее безуспешно. В сети перерыл все и нашел публикации земляка А. Кузнецова, из коих следовало, что все не так уж и плохо, сырье для лекарства растет не за горами а рядом. Обзвонив районы, где места предположительно, по высотам и растительности похожи, нашел зацепку, где гриб можно найти. Поехал и к счастью нашел, где растут эти бесценные Яйца. Вот такое вступление, а дальше появилась вполне определенная цель, попробовать вырастить этот гриб, но совершенно не зная как сделать такое, сначала решил заняться решением проблемы сохранения живого мицелия, что бы иметь для экспериментов восполняемый материал. Без привязки к месту и сезону произрастания нужного гриба, это было отправной задачей. Все прошло не так уж и плохо, имея небольшую практику работы с мицелием шампиньонов, взял основы из этой практики, для работы с мицелием Веселки.
После первой удачной разведки, поехал в тайгу и насобирал яиц, параллельно взял образцы спорового материала с плодовых тел. По приезду домой, сразу решил начать работу с клонирования мицелия из фрагмента будущего гриба. Работал следующим образом: Подготовил агаравую среду и чашки петри, разрезал чистое и отмытое перекисью яйцо, вырезал фрагмент из центра "зародыша" опять искупал его в растворе перекиси 3% где то 15 мин и на агар. Все делал в максимально стерильных условиях. так как материал был довольно редкий, да и с клонами работать по другому нельзя.
Рецепт агаровой среды:
агар(900) 15 гр
стакан березовых опилок
2гр сухих дрожжей
10 гр фруктозы
1 литр воды
Варил опилки 30 мин, фильтрование, затем все остальное, долил воды до литра и по чашкам. Стерилизация ЧП. 20 мин в скороварке, остывание и инокуляция. Через 24 часа появился первый пух мицелия, все без заражений. через неделю 1/4 пластины уже было колонизировано. Ну а дальше все пошло ровно и правильно.




|
|
Александр Кузнецов |
|
|
Зарегистрирован: 23.10.2009
Сообщения: 6776
Откуда: Алтайский край, р.ц.Алтайское
|

|
29-04-2012, 16:39 |
 Заголовок сообщения: |
| Савелий писал(а): |
| Стерилизация ЧП. 20 мин в скороварке, остывание и инокуляция. Через 24 часа появился первый пух мицелия, все без заражений. через неделю 1/4 пластины уже было колонизировано. Ну а дальше все пошло ровно и правильно. |
Здорово, импровизированный автоклав из скороварки..
А какой выдерживали температурный режим культивирования в чашках?
И на счет "дальше", можно чуть подробней? Субстрат, температура культивирования...
|
|
Александр Кузнецов |
|
|
Зарегистрирован: 23.10.2009
Сообщения: 6776
Откуда: Алтайский край, р.ц.Алтайское
|

|
29-04-2012, 16:43 |
 Заголовок сообщения: |
| saulius писал(а): |
| В нижней части "яйца" есть "нитка" мицелия. Прошлой осенью положил такую нитку в пакетик с влажными опилками и она начала расти, ветвиться. Потом все куда то исчезло, может червяк какой то попал в пакетик и все сьел, но факт- мицелий размножается и от маленькой нитки. В опилках. |
Саулюс, вот что ответил Ребриев Ю.А. на Ваше сообщение:
| rebriev писал(а): |
... интересная информация о росте мицелиального тяжа на опилках! Можно попробовать конечно. Нидуляриевые очень хорошо растут при переносе части субстрата (гнилушка, дернина и пр.) с мицелием в другое место или даже в лабораторию во влажную камеру. Но им легче - мицелий "привык" к частой фрагментации, это ведь ксилотрофы и подстилочные сапротрофы. Веселки преимущественно сапротрофы гумусовые или на уплотненной достаточно сильно разложенной подстилке, мицелий видимо сильнее травмируется...
Но пытаться всегда можно!
...
Получение культуры из плодового тела - достаточно рутинная, отработанная сейчас процедура. Но вот имеет свои недостатки, как мы выяснили на прошлом опыте - нужно СВЕЖЕЕ плодовое тело! Возможность использования для этой цели мицелия, или мицелиальных тяжей интересна именно с точки зрения возможности, если можно так сказать, "отсроченного" посева. Т.е. сохраняясь в природе в сухом состоянии, теоретически мицелиальные тяжи могут и в лаборатории полежать некоторое время.
|
Последний раз редактировалось: Александр Кузнецов (02-05-2012, 10:10), всего редактировалось 1 раз
|
|
Савелий |
|
|
Зарегистрирован: 26.04.2012
Сообщения: 20
|

|
29-04-2012, 19:02 |
 Заголовок сообщения: |
",,,а дальше все пошло ровно и правильно." Это относительно роста мицелия, на агаровой среде. С подбором субстрата, все оказалось не так просто, где то в глубине души я это чувствовал, так гладко всё не бывает. Но вернемся к чашкам и средам. На протяжении многократного переноса мицелия, выяснилась приятная особенность мицелия, успешно противостоять контаминации. В моем случае, в одной ЧП произошло заражение, судя по темно-зеленому цвету-триходермой (Trichoderma lignorum). Две культуры развивались одновременно не плохо, пока границы мицелия не коснулись друг друга. Дальше началось самое приятное, мицелий Веселки начал охватывать мицелий трихи с флангов и через некоторое время окружил колонию, а затем накрыл ее полностью с верху. Таким образом, конкурент за питание был устранен. В дальнейшем этот факт, очень облегчил работу с культурой Веселки, когда дело дошло до субстрата. Сам мицелий оказался не очень разборчив к агаровым средам, были испробованы бульоны для сред с картофеля,пшеницы, ржи, соломы, все оказалось одинаково хорошим питанием Тепературный режим, на протяжении проводимых опытов был разным. от + 4 С до 25 С.при низких температурах + 4 С, рост мицелия не останавливался, просто происходило сильное замедление его развития. Более плотный мицелий, рос при 15-20 С. На сегодня уже, букв написано много, остальное позже. Несколько снимков с прошлого года по теме

Яиц уже много а грибок пока один.

Забираем с него ароматный споровый материал

Ковер из мицелия под слоем листвы.

Яйца в ведре, уже дома

Не все доехали целыми.
|
|
Александр Кузнецов |
|
|
Зарегистрирован: 23.10.2009
Сообщения: 6776
Откуда: Алтайский край, р.ц.Алтайское
|

|
01-05-2012, 16:38 |
 Заголовок сообщения: |
| Савелий писал(а): |
| С подбором субстрата, все оказалось не так просто, где то в глубине души я это чувствовал, так гладко всё не бывает.. |
И какой же субстрат Веселке НЕ понравился?
|
|
Александр Кузнецов |
|
|
Зарегистрирован: 23.10.2009
Сообщения: 6776
Откуда: Алтайский край, р.ц.Алтайское
|

|
01-05-2012, 16:45 |
 Заголовок сообщения: |
| Савелий писал(а): |
| На протяжении многократного переноса мицелия, выяснилась приятная особенность мицелия, успешно противостоять контаминации. В моем случае, в одной ЧП произошло заражение, судя по темно-зеленому цвету-триходермой (Trichoderma lignorum). Две культуры развивались одновременно не плохо, пока границы мицелия не коснулись друг друга. Дальше началось самое приятное, мицелий Веселки начал охватывать мицелий трихи с флангов и через некоторое время окружил колонию, а затем накрыл ее полностью с верху. Таким образом, конкурент за питание был устранен.. |
Очень интересное наблюдение.. В открытом грунте это проследить практически невозможно.
А в условиях in vitro (в склянке) Ваш пример очень показателен. Значит антибиотики у Веселки посильнее чем у Триходермы... Действительно, приятный факт.
|
|
Paul |
|
|
Зарегистрирован: 03.12.2009
Сообщения: 445
Откуда: Волгоград, Светлый Яр
|

|
02-05-2012, 07:46 |
 Заголовок сообщения: |
Благодарю. Интересные исследования и практика.
|
|
Савелий |
|
|
Зарегистрирован: 26.04.2012
Сообщения: 20
|

|
02-05-2012, 08:08 |
 Заголовок сообщения: |
В этом сообщении, коснусь темы подбора формулы субстрата, для выросшего мицелия Веселки в чашках петри, .
Поиск сырья на роль субстрата начался на просторах сети, информации оказалось совсем не много. При ближайшем ознакомлении с этой информацией стало ясно, что ни о каком подробном рецепте приготовления речь не идет. По большей части все ограничивается общими формулировками по применению мульчи, опилок разных пород деревьев, даже органики из отходов пищевых продуктов и опавших плодов яблонь. Александр И, глядя на ваши фотографии мешков с мицелием, я тихо завидовал таким результатам и понимал, что все не так просто. Опилки даже удачно подобранные должны были пройти какую то предварительную подготовку. Подготовка могла включать в себя такие процессы как длительное замачивание, ферментация природная или искусственная, возможно даже пастеризация с последующей ферментацией. Особенно не радовали сроки приготовления маточного мицелия в таких объемах. Было очевидно, что при той скорости роста которая наблюдалась на агаровых средах, любой объем субстрата может быть колонизирован в гораздо меньшие сроки, надо только создать в субстрате множество точек роста с помощью маточного мицелия. Ну короче глаза боятся-руки делают. Для старта в эксперименте, первыми были взяты сосновые опилки, я их замочил на двое суток, слил воду и влил в них эмульсию приготовленную из мицелия с агаровой пластины и воды с помощью магнитной мешалки. Для контейнеров были использованы 2-х литровые пластиковые банки. Параллельно кинул в другую банку агаровые клинья с мицелием. В обоих случаях, мицелий в банках взял старт, появился свежи пух и дальше ни какой динамики в росте, потом мицелий просто исчез. Таким же образом были использованы опилки следующих пород древесины: яблоня, клен, тополь, вяз, береза. Результаты были разные но в общем отрицательные, либо очень медленный рост мицелия, причем нитевидного, он рос но складывалось такое впечатление что ему не хватает питания и он пускает свои тяжи в его поисках. Дальше был испробован пастеризованный и стерилизованный субстрат, все с тех же опилок, результат такой же. Когда мицелию субстрат приходится по вкусу, он начинает его колонизировать в точках инокуляции, продвигаясь дальше, обволакивая при этом захваченные участки ровным и плотным слоем, частицы субстрата в районе захвата мицелием пронизаны им полностью. В моем случае этого не происходило.
Дальше в ход пошел зерновой субстрат из пшеницы и ржи, приготовленный по стерильной технологии. Мицелий начинал свой рост в банках, но позже комковался и переставал расти. Позже выход был найден, рожь вперемешку с соломой и стерилизованная 90 мин, показала великолепный результат, банка с объемом субстрата в 1.5 литра заросла полностью за 3 недели. Вот таким образом, потратив относительно не очень много времени, всего около 3-х месяцев, был найден рецепт для маточного мицелия Веселки. С зерновым мицелием, проблем по по наращиванию массы мицелия с помощью разного рода опилок, уже было меньше. За зиму было произведено еще несколько опытов, рожь с соломой оказалась вне конкуренции на фоне других злаков. Опилки для зернового мицелия, подошли все о которых я упоминал выше. Уверен, что подходящих формул рецептов приготовления субстрата, для домашнего выращивания мицелия в домашних условиях, великое множество и мои личные опыты это капля в море на этом пути. Мой вывод по поводу эксперимента на удивление простой, затраченное мною время, могло быть гораздо меньшим, используя я для этого старые добрые рецепты приготовления субстрата для шампиньонов. Впереди же меня ждет, еще более интересная часть эксперимента и если повезет, то я смогу увидеть плодовые тела Веселки у себя на даче.
В этой банке рожь с соломой, инокуляция клином с агаровой пластины


В этих баночках, попытки выращивания мицелия на пастеризованных опилках разных пород. Не удачные по результатам.



В этом мешке пастеризованный опилочный субстрат из березовых опилок, заражение зерновым мицелием. Время захвата субстрата объемом 10 литров, на момент съемки 2.5 недели.

 |
Имя файла: 001.jpg
Размер файла: 86,52 KB
Скачано: 324 раз(а)
|
|
|
saulius |
|
|
Зарегистрирован: 25.10.2009
Сообщения: 239
|

|
02-05-2012, 09:01 |
 Заголовок сообщения: |
Благодарю, Савелий, очень интересные и познавательные опыты!
Я поступил проще. Осенью пойманый мицелий положил в коробки с почти свежими, влажными сосновыми опилками (никакой стерилизации) и в подвал. Кусок мицелием пропитаных опилок- примерно горсть на коробку 40 Х40 см, в середине. Зимой проверил- коробки полные мицелия, но не густо. Просто отделные нити уже достигли краев. Весной уже было гуще и все опилки с мицелием пошли в грядки. О одна коробка осталась (большинство мицелия выбрал, немножко оставил) на лето в саду- посмотрим как будет расти. С теми же сосновыми опилками без никакой подготовки. Периодически поливаю и все. Кстати, мицелий охватывает и стенки коробки- доска сосновая.
А в одну коробку осенью попожил не пойманый в опилках мицелий, а просто комок субстрата из под гриба с хорошо видным мицелием. Результат тот же- мицелий охватил не всю коробку, но явно размножился.
|
|
Александр Кузнецов |
|
|
Зарегистрирован: 23.10.2009
Сообщения: 6776
Откуда: Алтайский край, р.ц.Алтайское
|

|
02-05-2012, 09:53 |
 Заголовок сообщения: |
Благодарю друзья за описание проведенных опытов и наблюдений. Эта информация многим может очень пригодиться. Особенно тем садоводам кто захочет приручить Веселку в своем саду.
Очень рад такому продуктивному общению.
И очень хорошо и наглядно видно на фото. Размещайте побольше фотографий своих опытов. Какие есть.
|
|
Савелий |
|
|
Зарегистрирован: 26.04.2012
Сообщения: 20
|

|
02-05-2012, 10:02 |
 Заголовок сообщения: |
saulius
Да конечно такие варианты с опилками проходят, я убедился в этом, но в виду условий проживания в городской квартире, мне не куда ставить материал на длительное зарастание, поэтому и затеял весь сыр бор, по проверке быстроты колонизации субстрата. Был бы у меня подвал, наверное весной тоже увидел бы нормальный результат, на осенней закладке субстрата. Теперь вопрос скорости и мобильности решен, можно в течении лета сделать заброску мицелия в интересные с моей точки зрения места, по мимо дачного участка. Дальше в плане попробовать на всхожесть высохший споровый материал, который взял в прошлом году во время поездки.
|
|
Александр Кузнецов |
|
|
Зарегистрирован: 23.10.2009
Сообщения: 6776
Откуда: Алтайский край, р.ц.Алтайское
|

|
02-05-2012, 10:09 |
 Заголовок сообщения: |
| Савелий писал(а): |
| .. можно в течении лета сделать заброску мицелия в интересные с моей точки зрения места, по мимо дачного участка.. |
Очень хорошее решение..
Но, по мере роста грибов в саду происходит неизбежное расселение спор насекомыми по окрестным лесам...
|
|
Савелий |
|
|
Зарегистрирован: 26.04.2012
Сообщения: 20
|

|
02-05-2012, 12:45 |
 Заголовок сообщения: |
Чего то не сильно верится в успех предприятия на дачном участке, вернее будет, если высадку в подходящих местах продублировать. Находил я Веселку, неизвестного мне вида в городском парке, предполагаю что она туда завезена из других регионов нашей необъятной. Дело в том, что в 25 метрах от места находки, на протяжении последних 10 лет, находится летняя стоянка цирка Шапито, со всякими экзотическими животными, вероятно это эмигранты от цирковых мух.

|
|
|
|
|
|
|
 |
|
Вы не можете начинать темы
Вы не можете отвечать на сообщения
Вы не можете редактировать свои сообщения
Вы не можете удалять свои сообщения
Вы не можете голосовать в опросах
Вы не можете вкладывать файлы
Вы можете скачивать файлы
|
|
|